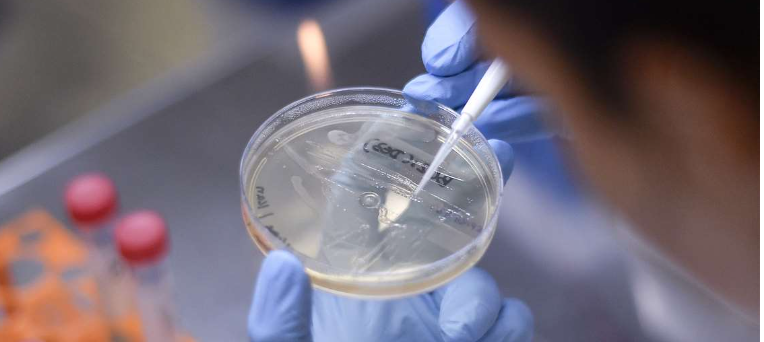

A Secretaria de Estado de Saúde do Acre (Sesacre) informou neste sábado, 6, que um novo caso suspeito da varíola dos macacos foi registrado. O paciente é um jovem de 21 anos, morador de Rio Branco, que deu entrada na Unidade de Pronto Atendimento (UPA) da Sobral na tarde de sexta-feira, 5, apresentando febre, fadiga e erupções cutâneas no corpo.